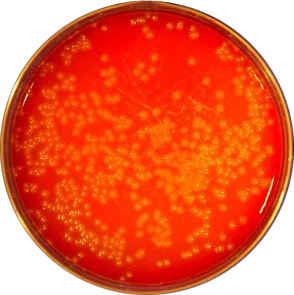
Beta hemolysis of Listeria monocytogenes - Beta-hemolytic colonies ofL. monocytogenes

Listeria monocytogenes is a facultative intracellular Gram-positive coccobacilliresponsible for listeriosis, one of the serious food-borne infections.
Other important distinguishing properties of this organism are as follows;
- It shows tumbling type of motility at 25°C but non-motile at 37°C (called differential motility, which is due to the temperature-dependent flagella expression).
- Unlike most other harmful bacteria, L. monocytogenesgrow slowly on foods stored in a refrigerator (4°C). It is commonly found in stored foods especially aged soft cheeses, packaged meats, milk, and cold salads.
- Growth improves if the specimen is refrigerated at 4°C and cultured at frequent intervals, this procedure is called cold enrichment.
- It shows a positiveCAMP testwhen streaked at a right angle to beta-hemolytic Staphylococcus aureus(enhanced arrowhead hemolysis).

Transmission
Listeria monocytogenes can be found in a variety of dairy products, vegetables, fish, and meat products. Unlike most other harmful bacteria, it can grow on foods stored in a refrigerator. Consumption of food contaminated with Listeria monocytogenes is the primary mode of transmission of listeriosis. Listerosis can also be transmitted from mother to fetus if infection occurs during pregnancy.
AsL. monocytogenesis able to cross the placenta, listeriosis is a major cause of perinatal and neonatal disease, typically resulting in abortion.
Pathogenesis
When ingested with contaminated foods, Listeria monocytogenesenter the epithelial cells lining gastrointestinal tracts including macrophages. It escapesfrom the phagosome, multiplies in the cytosol, and spreads directly to adjacent cells****thus protecting itself from antibodies and complement. Various proteins (virulence factors) of this organism play role in the pathogenesis.Find more here
Diseases
Listeriosis is one of the most serious foodborne diseases. Clinical manifestation of listerosis depends on the age of the patient and other underlying conditions such as pregnancy, immunosuppression, etc.
Depending on the immune status of the person and the part of the body affected, listeriosis can cause variety of symptoms ranging from milder flu-like illness to convulsion and death.
- Pregnant women: It affects both the mother and the fetus. Mother mostly experiences mild illness (flu-like symptoms) but it causes severe disease in the fetus or newborn baby (such as abortion, preterm delivery, newborn death, and neonatal meningitis).
- People other than pregnant women: Fever, muscle aches, headache, stiff neck, confusion, loss of balance, and convulsions.
Most people with invasive listeriosis require hospital care, and about one in five people with the infection die.
Laboratory Diagnosis
Sample: CSF, blood, feces or placental tissue or any other tissue specimens depending on the suspected disease and/or clinical presentation.
**Direct wet mount:**Listeria monocytogenesexhibits characteristic end-over-end tumbling motility when incubated in nutrient broth at room temperature for 1 to 2 hours. Presumptive identification of L. monocytogenescan be done by observation of such motility by direct wet mount.
Alternatively, suspected colonies ofL. monocytogenescan be stabbed into a tube of semisolid agar and incubated at 25°C for 18 hours. Characteristics umbrella-shaped motility pattern is seen after overnight incubation.
Gram staining: Regular, short, gram-positive rods or coccobacilli occurring in pairs (resembles streptococci).
Cold enrichmentCold enrichment is done for the isolation ofListeria monocytogenesfrom the placenta, tissues as well as specimens from heavily contaminated sources such as feces. The specimen is inoculated into a nutrient broth or trypticase soy broth and incubated at 4°C for one month and subcultured weekly.
Culture: Listeria monocytogenes can be cultured on conventional media incorporating sheep, horse or rabbit blood. Listeria monocytogenesproduces round, smooth, translucent colonies with a narrow zone of beta-hemolysis. Colonies are small and give blue-green color under reflective light.
Other characteristics that helps in the identification of this bacteria are:
- Catalase positive
- Voges-Proskauer-positive
- Esculin positive: L. monocytogenes is able to hydrolyze esculin in the presence of 40% bile. Esculin hydrolysis is indicated by the blackening of the medium.
- CAMP test positive
Molecular diagnosis
Detection of Listeria monocytogenesDNA in CSF and tissue (fresh or paraffin blocks)
Commercial methods
- AccuPROBE Listeria monocytogenes Culture Identification kit: Rapid DNA probe test, which utilizes the technique of nucleic acid hybridization for the identification of Listeria monocytogenes isolated from culture.
- Matrix-assisted laser desorption/ionization-time of flight (MALDI-TOF) method
- GeneQuence for Listeria monocytogenes
References and further readings
- Procop, G. W., & Koneman, E. W. (2016). Koneman’s Color Atlas and Textbook of Diagnostic Microbiology(Seventh, International edition). Lippincott Williams and Wilkins.
- Tille, P. (2017). Bailey & Scott’s Diagnostic Microbiology(14 edition). Mosby.
- Listeria (Listeriosis)| Listeria | CDC. (2020, March 10).